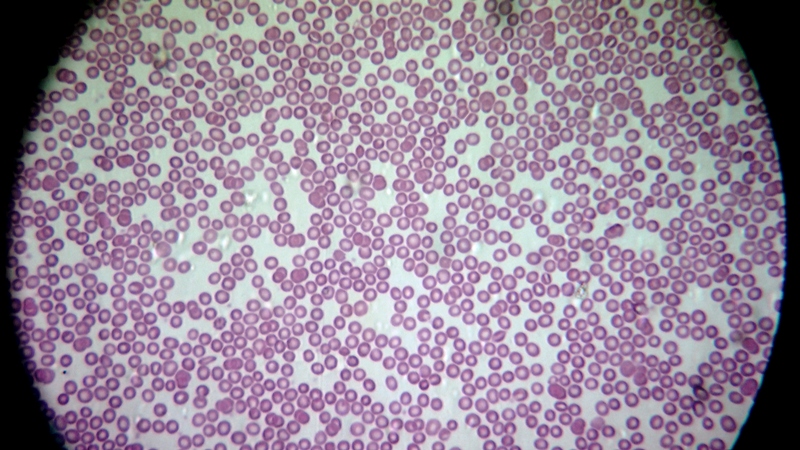
una cosa angosciosa e seria

|
|
|
|
|
Galleria Tassonomica
di
Natura Mediterraneo
|
|
|
| Autore |
 Discussione Discussione  |
|
|
Volvox
Utente Senior
   

Città: Pisa
Prov.: Pisa
Regione: Toscana

3685 Messaggi
Tutti i Forum |
 Inserito il - 02 giugno 2010 : 14:18:10 Inserito il - 02 giugno 2010 : 14:18:10


|
Cambia il titolo, ma l'angoscia permane. Vado ad illustrare.
Gli ingrandimenti indicati si riferiscono allo zoom della videocamera:
1x
Immagine:

42,72 KB
2x
Immagine:

72,82 KB
3x
Immagine:

87,75 KB
4x
Immagine:

126,98 KB
5x
Immagine:

121,85 KB
6x
Immagine:

120,26 KB
7x
Immagine:

131,15 KB
8x
Immagine:

136,13 KB
9x
Immagine:

143,34 KB
10x
Immagine:

150,68 KB
11x
Immagine:

131,34 KB
12x
Immagine:

132,94 KB
Dalla prima e dalla seconda si desume chiaramente che l'allineamento tra videocamera e microscopio è latrinesco, così come la lente interna alla testata, che ha bisogno di una bella pulita.
Volvox
"Omnia ab ovo".
Le còcce, pe' piacere, ner biologgico!
|
Modificato da - Volvox in Data 02 giugno 2010 14:23:06
|
|
|
escocat
Utente Super
    

Città: Messina
Prov.: Messina
Regione: Sicilia

6614 Messaggi
Tutti i Forum |
 Inserito il - 02 giugno 2010 : 14:28:15 Inserito il - 02 giugno 2010 : 14:28:15


|
Vorrei aiutarti ma non ho dimestichezza con le videocamere (figuriamoci su un microscopio) però mi sembra che a 3x e a 12x si possa fare qualcosa per migliorare. A 3x si dovrebbe fare in modo da "aprire" il campo spostando forse la posizione della videocamera, invece a 12x si dovrebbe rendere più definito il bordo del campo ed aumentare la luminosità. Oltre i 10x mi sembra che la definizione sia buona. Ma aspettiamo gli esperti. Io soffro con te (ormai da lungo tempo ...)
Tanto più piccolo è ciò che osserviamo, tanto più grandi saremo. |
 |
|
|
enotria
Utente Senior
   

Città: Gaibanella FE
Prov.: Ferrara
Regione: Emilia Romagna

1322 Messaggi
Tutti i Forum |
 Inserito il - 03 giugno 2010 : 00:04:59 Inserito il - 03 giugno 2010 : 00:04:59


|
Dire che poteva andare peggio è un eufemismo.
Per quell'oculare la posizione giusta per lo zoom è a 4x ( a 3x va già bene, ma la luce è ancora mal distribuita)
In queste condizioni, prova ad alzare/abbassare l'altezza del condensatore per vedere se il campo si ripulisce da tutto quello sporco, pardon, monnezza.
Hai provato altri oculari con pupilla più o meno alta ed ingrandimento più o meno spinto ? Le condizioni migliori sono sempre con lo zoom a 4x ?
Tieni d'occhio quei cerchi che si vedono quando aumenti l'ingrandimento dei particolari tirando lo zoom, sono molto antipatici, vedi se puoi eliminarli.
Cordiali saluti
Andrea ---> Link
Ogni oggetto ha la sua storia,
. . . io non vendo oggetti,
. . . . . . io racconto storie. (Enotria) |
 |
|
|
diatomea
Utente Senior
   

Città: milano

2303 Messaggi
Tutti i Forum |
 Inserito il - 03 giugno 2010 : 13:28:08 Inserito il - 03 giugno 2010 : 13:28:08


|
Ciao Franco,
concordo con Enotria, il giusto ingrandimento è quello indicato come 3x e 4x, andando oltre, vai oltre il vetrino e finisci per mettere a fuoco la lente del condensatore sottostante il vetrino stesso.
Io credo che diminuendo la distanza fra la telecamera e il micro (quindi riducendo la lunghezza del terzo tubo dovresti riuscire ad avere un'immaine corretta senza vignettatura...
Ciao
Davide
Link
|
 |
|
|
Volvox
Utente Senior
   

Città: Pisa
Prov.: Pisa
Regione: Toscana

3685 Messaggi
Tutti i Forum |
 Inserito il - 03 giugno 2010 : 23:37:28 Inserito il - 03 giugno 2010 : 23:37:28


|
| Messaggio originario di diatomea:
...riducendo la lunghezza del terzo tubo dovresti riuscire ad avere un'immagine corretta senza vignettatura... |
Purtroppo no, ahimé: ottengo solo un immagine sfocata (non correggibile con il fuoco manuale della videocamera) rispetto a quella degli oculari e con vignettatura!
Volvox
"Omnia ab ovo".
Le còcce, pe' piacere, ner biologgico! |
 |
|
|
enotria
Utente Senior
   

Città: Gaibanella FE
Prov.: Ferrara
Regione: Emilia Romagna

1322 Messaggi
Tutti i Forum |
 Inserito il - 03 giugno 2010 : 23:59:41 Inserito il - 03 giugno 2010 : 23:59:41


|
| | non correggibile con il fuoco manuale della videocamera |
Non devi correggere la messa a fuoco con la videocamera, la videocamera va lasciata fissa su infinito !
    
Se proprio devi correggere la messa a fuoco, lo puoi fare allungando/accorciando il raccordo, oppure, piuttosto, tappati il naso e modifica la messa a fuoco del microscopio.
Cordiali saluti
Andrea ---> Link
Ogni oggetto ha la sua storia,
. . . io non vendo oggetti,
. . . . . . io racconto storie. (Enotria) |
Modificato da - enotria in data 04 giugno 2010 00:03:13 |
 |
|
|
Volvox
Utente Senior
   

Città: Pisa
Prov.: Pisa
Regione: Toscana

3685 Messaggi
Tutti i Forum |
 Inserito il - 04 giugno 2010 : 00:37:43 Inserito il - 04 giugno 2010 : 00:37:43


|
Me so' rintanato 'n garace, sperando de nun èsse' raggiunto da 'i strali d'Enotria, ma poi so' riemerso per assicuraje che non proverò mai più - me possino ciecamme! - a mette' a fòco co' 'a messa a òoco manuale da a videocammera! E che so' scemo? Mo 'o dovessi aritrovà' fòri da 'a porta de casa co' 'e mani a li fianchi e co' 'a roncola in mano!
Vorvocchese
"Omnia ab ovo".
Le còcce, pe' piacere, ner biologgico! |
 |
|
|
enotria
Utente Senior
   

Città: Gaibanella FE
Prov.: Ferrara
Regione: Emilia Romagna

1322 Messaggi
Tutti i Forum |
 Inserito il - 04 giugno 2010 : 06:43:04 Inserito il - 04 giugno 2010 : 06:43:04


|
E stai attento che ti tengo d'occhio !   
Buon lavoro
Andrea
Andrea ---> Link
Ogni oggetto ha la sua storia,
. . . io non vendo oggetti,
. . . . . . io racconto storie. (Enotria) |
 |
|
|
Volvox
Utente Senior
   

Città: Pisa
Prov.: Pisa
Regione: Toscana

3685 Messaggi
Tutti i Forum |
 Inserito il - 04 giugno 2010 : 11:13:22 Inserito il - 04 giugno 2010 : 11:13:22


|
Mi sa che questo è il massimo cui posso aspirare in campo chiaro:
Immagine:

208,16 KB
Immagine:

217,88 KB
Immagine:

201,58 KB
Immagine:

194,1 KB
Immagine:

53,97 KB
Volvox
"Omnia ab ovo".
Le còcce, pe' piacere, ner biologgico! |
 |
|
|
diatomea
Utente Senior
   

Città: milano

2303 Messaggi
Tutti i Forum |
 Inserito il - 04 giugno 2010 : 11:33:52 Inserito il - 04 giugno 2010 : 11:33:52


|
...non mi sembra poi male...in modo particolare l'ultima...davvero ben riuscita!
ciao
Davide
Link
|
 |
|
|
escocat
Utente Super
    

Città: Messina
Prov.: Messina
Regione: Sicilia

6614 Messaggi
Tutti i Forum |
 Inserito il - 04 giugno 2010 : 11:42:02 Inserito il - 04 giugno 2010 : 11:42:02


|
Se uno non riesce a fare una foto non se la deve prendere coi gattini, avvelenandoli. 6 1 MOSTRO!
Dalla terza in poi il cerchio di campo è sparito e questa è cosa buona. Ma lo zoom della videocamera mi sembra troppo spinto a scapito della nitidezza e questa è cosa non buona. Credo proprio che tu non debba superare uno zoom 3-4x, e fare in modo di "allargare" il cerchio utilizzando qualche oculare è regolando le varie distanze. Ma è proprio necessario usare QUESTA videocamera? Perchè non usi QUELLA di Art?
Tanto più piccolo è ciò che osserviamo, tanto più grandi saremo. |
 |
|
|
geppe
Moderatore
    

Città: lesmo
Prov.: Milano
Regione: Lombardia

5413 Messaggi
Tutti i Forum |
 Inserito il - 04 giugno 2010 : 16:06:58 Inserito il - 04 giugno 2010 : 16:06:58


|
ciao,
mi sembra che ci stai arrivando,
con l'effetto video saranno poi molto meglio rispetto all'immagine statica.
tanto per avere un idea, che obbiettivo avevi montato sul micro in quegli scatti ?
Giuseppe |
 |
|
|
Volvox
Utente Senior
   

Città: Pisa
Prov.: Pisa
Regione: Toscana

3685 Messaggi
Tutti i Forum |
 Inserito il - 05 giugno 2010 : 09:10:58 Inserito il - 05 giugno 2010 : 09:10:58


|
I Signori Amministratori sono pregati di non rompere: trattasi di vetrini preparati aliunde, ma mi servono per prove tecniche di fotomicrografia:
Immagine:

279,02 KB
Immagine:

287,66 KB
Immagine:

289,62 KB
Immagine:

254,43 KB
Immagine:

281,89 KB
Immagine:
277,39 KB
Volvox
"Omnia ab ovo".
Le còcce, pe' piacere, ner biologgico! |
 |
|
|
enotria
Utente Senior
   

Città: Gaibanella FE
Prov.: Ferrara
Regione: Emilia Romagna

1322 Messaggi
Tutti i Forum |
 Inserito il - 05 giugno 2010 : 23:13:50 Inserito il - 05 giugno 2010 : 23:13:50


|
Bè, mi pare che stiamo migliorando.
Non so la posizione del tuo zoom, se era basso (3x-4x) andiamo bene, hai già tutto il campo ed ancora hai la possibilità di ingrandire. Se invece era già alto (8x ed oltre) andiamo male, devi provare altri oculari.
Puoi provare anche con altri gruppi di lenti, del resto non è affatto obbligatorio che le lenti intermedie fra microscopio e cinepresa si debbano chiamare per forza oculare.
Può essere benissimo un obiettivo da proiettore (soluzione Arturo), un obiettivo da binocolo (soluzione Sini), un obiettivo da fotocopiatrice (soluzione Enotria), un obiettivo da ingranditore, ecc. ecc.
L'importante è che il gruppo sia ben corretto e che svolga nel miglior modo il suo lavoro di accoppiare il microscopio alla cinepresa.
Verifica anche la distribuzione della luminosità all'interno del campo, mi sembra che nella foto dei globuli rossi vi sia un centro molto luminoso mentre i bordi calino di un paio di Stop.
In caso inquadra un campo uniforme, ad esempio un foglio di carta colorata, meglio se sottoesponi e, se noti cali di luminosità ai bordi, verifica tutto il sistema di illuminazione, dalla lampada fino all'altezza del condensatore.
Fai i miei auguri alla tua signora, io ci sono passato alcuni anni fa e so che è fin troppo brava. Lei !
Cordiali saluti
Andrea ---> Link
Ogni oggetto ha la sua storia,
. . . io non vendo oggetti,
. . . . . . io racconto storie. (Enotria) |
 |
|
|
Volvox
Utente Senior
   

Città: Pisa
Prov.: Pisa
Regione: Toscana

3685 Messaggi
Tutti i Forum |
 Inserito il - 05 giugno 2010 : 23:54:28 Inserito il - 05 giugno 2010 : 23:54:28


|
| Messaggio originario di enotria:
...Bè, mi pare che stiamo migliorando ...Non so la posizione del tuo zoom, se era basso (3x-4x) andiamo bene ... |
Grazie, Andrea. Nelle immagini, lo zoom della videocamera è nell'àmbito del 4x e inquadra l'intero campo dell'oculare del microscopio (inevitabilmente tagliato nelle parti in alto e in basso dal formato 16/9), precisando che l'oculare è quello a pupilla alta Carboni-Sini. Ho provato gli oculari da te cortesemente prestatimi, ma, con tutti, per coprire similmente il campo della videocamera, occorre spingere esageratamente lo zoom, peggiorando la qualità dell'immagine e restringendo perniciosamente il campo microscopico visibile.
Inoltre, ho finalmente rintracciato parametri della videocamera (devo farci la mano e l'occhio, mica è facile come sembra!) che promettono bene in termini di resa qualitativa.
Adesso, devo trovare invasi idonei allo scopo: con tutta la pioggia che è caduta da queste parti durante l'inverno e la primavera, non si trovano raccolte d'acqua in cui i microrganismi si siano opportunamente concentrati, come auspicato dalla comodità del microscopista impaziente e inc....to!
Ti ringrazio, altresì, degli auguri per la Consorte: l'impresa non è stata semplice! Martedì prossimo andiamo a togliere la settantina di punti con cui le hanno ricamato l'addome.
Volvox
"Omnia ab ovo".
Le còcce, pe' piacere, ner biologgico! |
Modificato da - Volvox in data 06 giugno 2010 00:04:43 |
 |
|
|
Volvox
Utente Senior
   

Città: Pisa
Prov.: Pisa
Regione: Toscana

3685 Messaggi
Tutti i Forum |
 Inserito il - 06 giugno 2010 : 15:34:01 Inserito il - 06 giugno 2010 : 15:34:01


|
Oggi, per la prima volta dall'intervento, ho portato a spasso (in macchina) mia moglie per i dintorni di Pisa (anche alla ricerca d'invasi interessanti, che, però, non ho trovato) e ne ho approfittato per testare la qualità delle riprese panoramiche in luce solare della Panasonic, esaminandole su televisore 1080p: devo dire, eccellenti! Sembra di essere sul posto con i propri occhi, ma senza i difetti propri dell'età di questi ultimi!
Adesso, c'è da ricercare la medesima perfezione nelle riprese al microscopio, e l'impresa non è sicuramente una passeggiata!
Volvox
"Omnia ab ovo".
Le còcce, pe' piacere, ner biologgico! |
 |
|
| |
 Discussione Discussione  |
|
|
|
 Natura Mediterraneo Natura Mediterraneo |
© 2003-2024 Natura Mediterraneo |
 |
|
Leps.it | Herp.it | Lynkos.net
|

 Forum
|
Registrati
|
Msg attivi
|
Msg Recenti
|
Msg Pvt
|
Utenti
|
Galleria |
Map |
Forum
|
Registrati
|
Msg attivi
|
Msg Recenti
|
Msg Pvt
|
Utenti
|
Galleria |
Map |